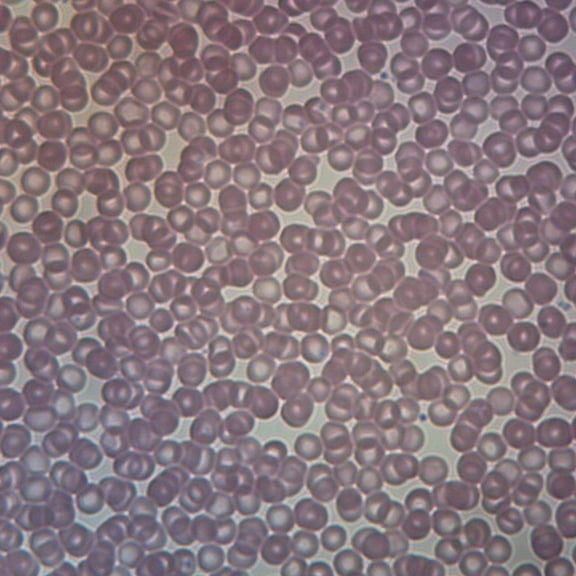
Human Iron Deficiency Anemia, Smear Microscope Slide

Hero image 0 of Mammal Cerebrum Pyramidal Neurons, Sec. 7 M Silver Stain Microscope Slide, 0 of 1
Mammal Cerebrum Pyramidal Neurons, Sec. 7 M Silver Stain Microscope Slide
Current price is USD$21.40
Price when purchased online
- Free 30-day returns
How do you want your item?
Columbus, 43215
Arrives by Fri, Apr 10
|Shipping fee $8.95
Sold and shipped by Carolina Biological Supply Company
4.314814814814815 stars out of 5, based on 162 seller reviews(4.3)
Free 30-day returns
About this item
Customer ratings & reviews
1 out of 5 stars
How item rating is calculated
Sort by |
Showing 1-1 of 1 review
Jan 26, 2024
Spencer CL
1 out of 5 stars review
Seller Verified Purchase
Poor QC
Review from carolina.com
Helpful?
reply from Slides